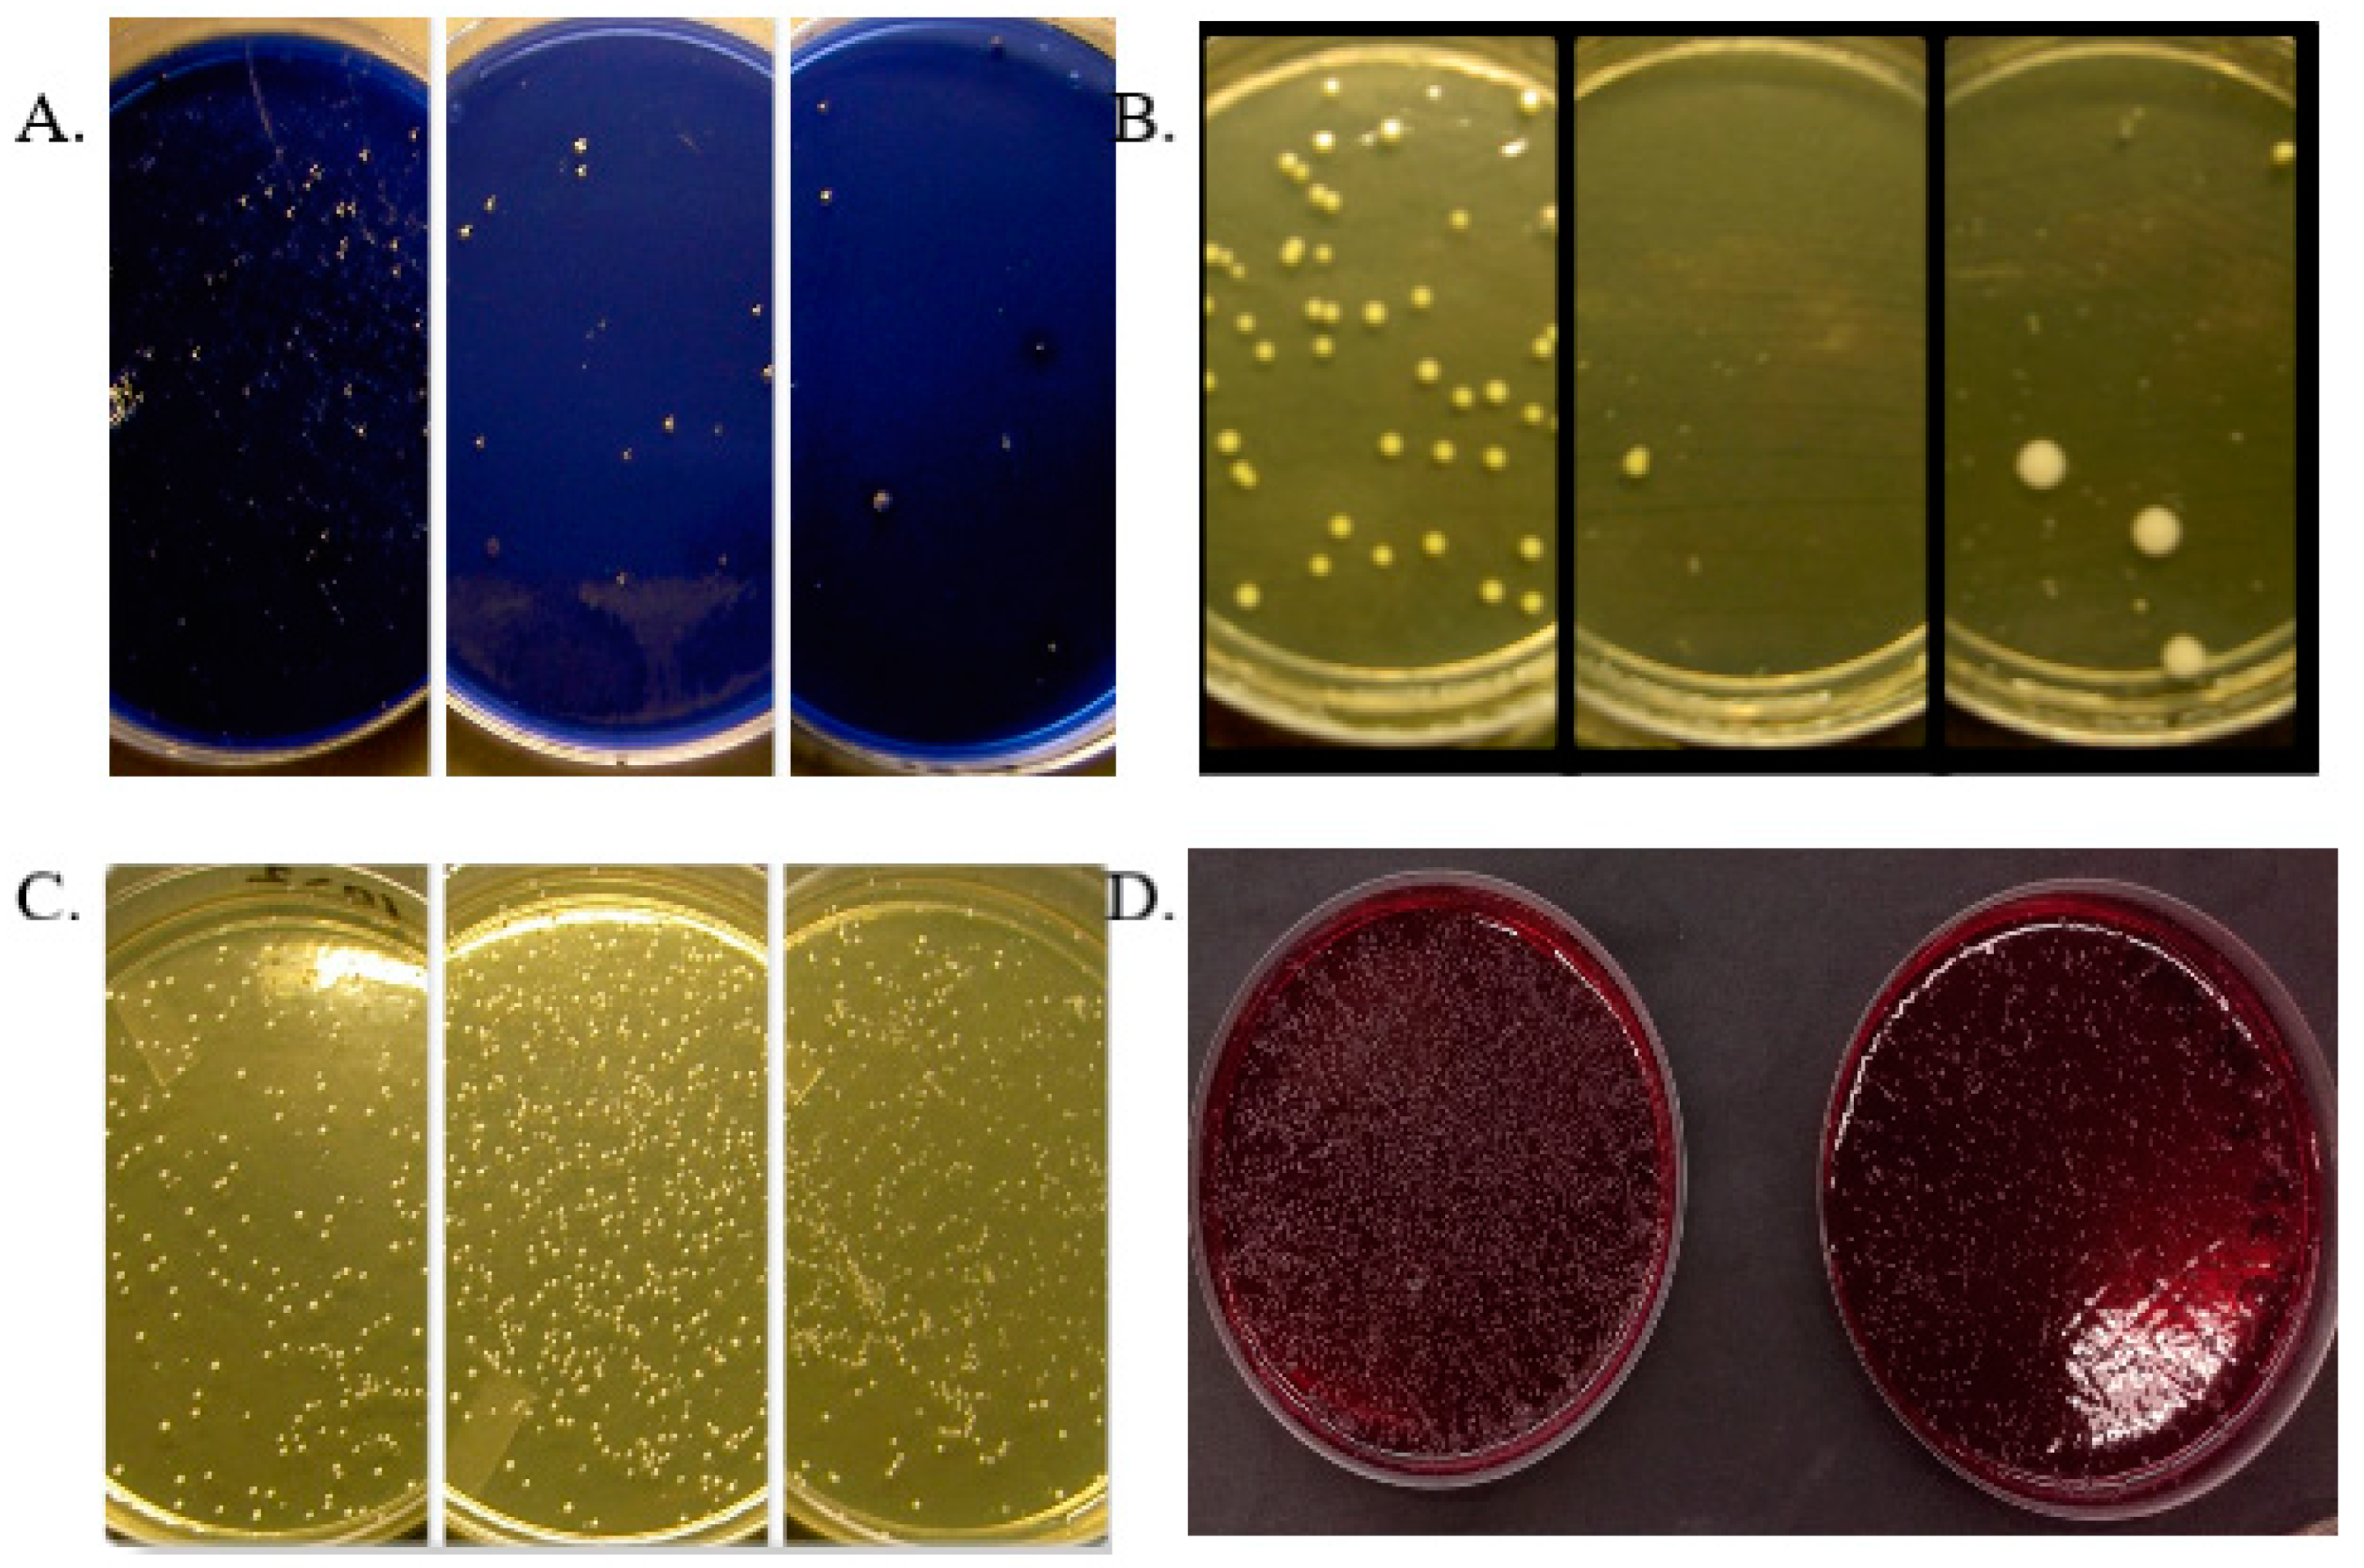
Microorganisms 12 01850 g001

Lingonberry (Vaccinium vitis-idaea L.) Fruit Phenolic Bioactivities—A Review of In Vitro and In Vivo Human Studies
Abstract
1. Introduction
2. In Vitro Studies
2.1. Antioxidant and Cancer Cell Studies
2.2. Effects on the Liver, Chronic Low-Grade Inflammation, Overweight and Diabetes Risk
2.3. Antimicrobial Effects
3. Clinical Human Trials
3.1. Oral Effects
3.2. Effects of Fermented Lingonberry Juice on Oral Microbes
4. Discussion
Author Contributions
Funding
Acknowledgments
Conflicts of Interest
References
- Ek, S.; Kartimo, H.; Mattila, S.; Tolonen, A. Characterization of phenolic compounds from lingonberry (Vaccinum vitis-idaea). J. Agric. Food Chem. 2006, 54, 9834–9842. [Google Scholar] [CrossRef]
- Kylli, P.; Nohynek, L.; Puupponen-Pimiä, R.; Westerlund-Wikström, B.; Leppänen, T.; Welling, J.; Moilanen, E.; Heinonen, M. Lingonberry (Vaccinium vitis-idaea) and European cranberry (Vaccinium microcarpon) proanthocyanidins: Isolation, identification, and bioactivities. J. Agric. Food Chem. 2011, 59, 3373–3384. [Google Scholar] [CrossRef] [PubMed]
- Amundsen, M.; Hykkerud, A.L.; Kelanne, N.; Tuominen, S.; Schmidt, G.; Laaksonen, O.; Yang, B.; Martinussen, I.; Jaakola, L.; Aaby, K. Composition of Sugars, Organic Acids, Phenolic Compounds, and Volatile Organic Compounds in Lingonberries (Vaccinium vitis-idaea L.) at Five Ripening Stages. Foods 2023, 12, 2154. [Google Scholar] [CrossRef] [PubMed]
- Brown, E.M.; Nitecki, S.; Pereira-Caro, G.; McDougall, G.J.; Stewart, D.; Rowland, I.; Crozier, A.; Gill, C.I. Comparison of in vivo and in vitro digestion on polyphenol composition in lingonberries: Potential impact on colonic health. BioFactors 2014, 40, 611–623. [Google Scholar] [CrossRef]
- Lehtonen, H.M.; Rantala, M.; Suomela, J.P.; Viitanen, M.; Kallio, H. Urinary excretion of the main anthocyanin in lingonberry (Vaccinium vitis-idaea), cyanidin 3-O-galactoside, and its metabolites. J. Agric. Food Chem. 2009, 57, 4447–4451. [Google Scholar] [CrossRef]
- Brown, P.N.; Turi, C.E.; Shipley, P.R.; Murch, S.J. Comparisons of large (Vaccinium macrocarpon Ait.) and small (Vaccinium oxycoccos L., Vaccinium vitis-idaea L.) cranberry in British Columbia by phytochemical determination, antioxidant potential, and metabolomic profiling with chemometric analysis. Planta Medica 2012, 78, 630–640. [Google Scholar] [CrossRef]
- Laitinen, L.A.; Tammela, P.S.; Galkin, A.; Vuorela, H.J.; Marvola, M.L.; Vuorela, P.M. Effects of extracts of commonly consumed food supplements and food fractions on the permeability of drugs across Caco-2 cell monolayers. Pharm. Res. 2004, 21, 1904–1916. [Google Scholar] [CrossRef]
- Di Meo, F.; Valentino, A.; Petillo, O.; Peluso, G.; Filosa, S.; Crispi, S. Bioactive Polyphenols and Neuromodulation: Molecular Mechanisms in Neurodegeneration. Int. J. Mol. Sci. 2020, 21, 2564. [Google Scholar] [CrossRef] [PubMed]
- Heinonen, M. Antioxidant activity and Antimicrobial effect of berry phenolics—A Finnish perspective. Mol. Nutr. Food Res. 2007, 51, 684–691. [Google Scholar] [CrossRef]
- Ames, B.N.; Shigenaga, M.K.; Hagen, T.M. Oxidants, antioxidants, and the degenerative diseases of aging. Proc. Natl. Acad. Sci. USA 1993, 90, 7915–7922. [Google Scholar] [CrossRef]
- Määttä-Riihinen, K.R.; Kähkönen, M.P.; Törrönen, A.R.; Heinonen, I.M. Catechins and procyanidins in berries of Vaccinium species and their antioxidant activity. J. Agric. Food Chem. 2005, 53, 8485–8491. [Google Scholar] [CrossRef] [PubMed]
- Kostka, T.; Ostberg-Potthoff, J.J.; Stärke, J.; Guigas, C.; Matsugo, S.; Mirčeski, V.; Stojanov, L.; Veličkovska, S.K.; Winterhalter, P.; Esatbeyoglu, T. Bioactive Phenolic Compounds from Lingonberry (Vaccinium vitis-idaea L.): Extraction, Chemical Characterization, Fractionation and Cellular Antioxidant Activity. Antioxidants 2022, 11, 467. [Google Scholar] [CrossRef] [PubMed]
- Wang, S.Y.; Feng, R.; Bowman, L.; Penhallegon, R.; Ding, M.; Lu, Y. Antioxidant activity in lingonberries (Vaccinium vitis-idaea L.) and its inhibitory effect on Activator protein-1, nuclear factor-kappaB, and mitogen-activated protein kinases activation. J. Agric. Food Chem. 2005, 53, 3156–3166. [Google Scholar] [CrossRef]
- Hoornstra, D.; Vesterlin, J.; Pärnänen, P.; Al-Samadi, A.; Zlotogorski-Hurvitz, A.; Vered, M.; Salo, T. Fermented lingonberry juice inhibits oral tongue squamous cell carcinoma invasion in vitro similarly to curcumin. In Vivo 2018, 32, 1089–1095. [Google Scholar] [CrossRef]
- Olsson, M.E.; Gustavsson, K.E.; Andersson, S.; Nilsson, A.; Duan, R.D. Inhibition of cancer cell proliferation in vitro by fruit and berry extracts and correlations with antioxidant levels. J. Agric. Food Chem. 2004, 52, 7264–7271. [Google Scholar] [CrossRef] [PubMed]
- McDougall, G.J.; Ross, H.A.; Ikeji, M.; Stewart, D. Berry extracts exert different antiproliferative effects against cervical and colon cancer cells grown in vitro. J. Agric. Food Chem. 2008, 56, 3016–3023. [Google Scholar] [CrossRef]
- Fan, Z.L.; Wang, Z.Y.; Liu, J.R. Cold-field fruit extracts exert different antioxidant and antiproliferative activities in vitro. Food Chem. 2011, 129, 402–407. [Google Scholar] [CrossRef]
- Minker, C.; Duban, L.; Karas, D.; Järvinen, P.; Lobstein, A.; Muller, C.D. Impact of Procyanidins from Different Berries on Caspase 8 Activation in Colon Cancer. Oxid. Med. Cell. Longev. 2015, 2015, 154164. [Google Scholar] [CrossRef]
- Vilkickyte, G.; Raudone, L.; Petrikaite, V. Phenolic Fractions from Vaccinium vitis-idaea L. and Their Antioxidant and Anticancer Activities Assessment. Antioxidants 2020, 9, 1261. [Google Scholar] [CrossRef]
- Ho, G.T.T.; Nguyen, T.K.Y.; Kase, E.T.; Tadesse, M.; Barsett, H.; Wangensteen, H. Enhanced Glucose Uptake in Human Liver Cells and Inhibition of Carbohydrate Hydrolyzing Enzymes by Nordic Berry Extracts. Molecules 2017, 22, 1806. [Google Scholar] [CrossRef]
- Kowalska, K.; Dembczyński, R.; Gołąbek, A.; Olkowicz, M.; Olejnik, A. ROS Modulating Effects of Lingonberry (Vaccinium vitis-idaea L.) Polyphenols on Obese Adipocyte Hypertrophy and Vascular Endothelial Dysfunction. Nutrients 2021, 13, 885. [Google Scholar] [CrossRef] [PubMed]
- Beaulieu, L.P.; Harris, C.S.; Saleem, A.; Cuerrier, A.; Haddad, P.S.; Martineau, L.C.; Bennett, S.A.; Arnason, J.T. Inhibitory effect of the Cree traditional medicine wiishichimanaanh (Vaccinium vitis-idaea) on advanced glycation endproduct formation: Identification of active principles. Phytother. Res. 2010, 24, 741–747. [Google Scholar] [CrossRef] [PubMed]
- Ryyti, R.; Hämäläinen, M.; Leppänen, T.; Peltola, R.; Moilanen, E. Phenolic Compounds Known to Be Present in Lingonberry (Vaccinium vitis-idaea L.) Enhance Macrophage Polarization towards the Anti-Inflammatory M2 Phenotype. Biomedicines 2022, 10, 3045. [Google Scholar] [CrossRef] [PubMed]
- Westfall, S.; Lomis, N.; Kahouli, I.; Dia, S.Y.; Singh, S.P.; Prakash, S. Microbiome, probiotics and neurodegenerative diseases: Deciphering the gut brain axis. Cell. Mol. Life Sci. 2017, 74, 3769–3787. [Google Scholar] [CrossRef]
- Mortaz, E.; Adcock, I.M.; Folkerts, G.; Barnes, P.J.; Paul Vos, A.; Garssen, J. Probiotics in the management of lung diseases. Mediat. Inflamm. 2013, 2013, 751068. [Google Scholar] [CrossRef] [PubMed]
- Puupponen-Pimiä, R.; Nohynek, L.; Meier, C.; Kähkönen, M.; Heinonen, M.; Hopia, A.; Oksman-Caldentey, K.M. Antimicrobial properties of phenolic compounds from berries. J. Appl. Microbiol. 2001, 90, 494–507. [Google Scholar] [CrossRef]
- Puupponen-Pimiä, R.; Nohynek, L.; Hartmann-Schmidlin, S.; Kähkönen, M.; Heinonen, M.; Määttä-Riihinen, K.; Oksman Caldentey, K.M. Berry phenolics selectively inhibit the growth of intestinal pathogens. J. Appl. Microbiol. 2005, 98, 991–1000. [Google Scholar] [CrossRef]
- Toivanen, M.; Huttunen, S.; Lapinjoki, S.; Tikkanen-Kaukanen, C. Inhibition of adhesion of Neisseria meningitidis to human epithelial cells by berry juice polyphenolic fractions. Phytother. Res. 2011, 25, 828–832. [Google Scholar] [CrossRef]
- Kokubu, E.; Kinoshita, E.; Ishihara, K. Inhibitory Effects of Lingonberry Extract on Oral Streptococcal Biofilm Formation and Bioactivity. Bull. Tokyo Dent. Coll. 2019, 60, 1–9. [Google Scholar] [CrossRef]
- Pärnänen, P.; Sorsa, T.; Tervahartiala, T.; Nikula-Ijäs, P. Isolation, characterization and regulation of moonlighting proteases from Candida glabrata cell wall. Microb. Pathog. 2020, 149, 104547. [Google Scholar] [CrossRef]
- Nikolaeva-Glomb, L.; Mukova, L.; Nikolova, N.; Badjakov, I.; Dincheva, I.; Kondakova, V.; Doumanova, L.; Galabov, A.S. In vitro antiviral activity of a series of wild berry fruit extracts against representatives of Picorna-, Orthomyxo- and Paramyxoviridae. Nat. Prod. Commun. 2014, 9, 51–54. [Google Scholar] [CrossRef] [PubMed]
- Törrönen, R.; Kolehmainen, M.; Sarkkinen, E.; Mykkänen, H.; Niskanen, L. Postprandial glucose, insulin, and free fatty acid responses to sucrose consumed with blackcurrants and lingonberries in healthy women. Am. J. Clin. Nutr. 2012, 96, 527–533. [Google Scholar] [CrossRef] [PubMed]
- Törrönen, R.; Kolehmainen, M.; Sarkkinen, E.; Poutanen, K.; Mykkänen, H.; Niskanen, L. Berries reduce postprandial Insulin Responses to wheat and Rye breads in healthy women. J. Nutr. 2013, 143, 430–436. [Google Scholar] [CrossRef] [PubMed]
- Davidson, E.; Zimmermann, B.F.; Jungfer, E.; Chrubasik-Hausmann, S. Prevention of urinary tract infections with Vaccinium products. Phytother. Res. 2014, 28, 465–470. [Google Scholar] [CrossRef]
- Pärnänen, P.; Suojanen, J.; Laine, M.; Sorsa, T.; Ranki, A. Long-term remission of candidiasis with fermented lingonberry mouth rinse in an adult patient with APECED. Int. J. Infect. Dis. 2024, 144, 107066. [Google Scholar] [CrossRef] [PubMed]
- Vainionpää, A.; Tuomi, J.; Kantola, S.; Anttonen, V. Neonatal thrush of newborns: Oral candidiasis? Clin. Exp. Dent. Res. 2019, 5, 580–582. [Google Scholar] [CrossRef]
- Pärnänen, P.; Nikula-Ijäs, P.; Sorsa, T. Antimicrobial and anti-inflammatory lingonberry mouthwash—A clinical pilot study in the oral cavity. Microorganisms 2019, 7, 331. [Google Scholar] [CrossRef]
- Pärnänen, P.; Lomu, S.; Räisänen, I.T.; Tervahartiala, T.; Sorsa, T. Effects of Fermented Lingonberry Juice Mouthwash on Salivary Parameters—A One-Year Prospective Human Intervention Study. Dent. J. 2022, 10, 69. [Google Scholar] [CrossRef]
- Pärnänen, P.; Lomu, S.; Räisänen, I.T.; Tervahartiala, T.; Sorsa, T. Antimicrobial and anti-inflammatory oral effects of fermented lingonberry juice—A one-year prospective human intervention study. Eur. J. Dent. 2023, 17, 1235–1240. [Google Scholar] [CrossRef]
- Lähteenmäki, H.; Tervahartiala, T.; Räisänen, I.T.; Pärnänen, P.; Sorsa, T. Fermented lingonberry juice’s effects on active MMP-8 (aMMP-8), bleeding on probing (BOP), and visible plaque index (VPI) in dental implants—A clinical pilot mouthwash study. Clin. Exp. Dent. Res. 2022, 8, 1322–1330. [Google Scholar] [CrossRef]
- Berries United’s lingonberry mouthwash is effective against yeast, plaque, bacteria and oral tissue-destructive enzymes. Br. Dent. J. 2024, 236, 493. [CrossRef]
- Bratthall, D.; Hänsel Petersson, G. Cariogram—A multifactorial risk assessment model for a multifactorial disease. Community Dent. Oral Epidemiol. 2005, 33, 256–264. [Google Scholar] [CrossRef]
- Sorsa, T.; Nwhator, S.O.; Sakellari, D.; Grigoriadis, A.; Umeizudike, K.A.; Brandt, E.; Keskin, M.; Tervahartiala, T.; Pärnänen, P.; Gupta, S.; et al. aMMP-8 Oral Fluid PoC Test in Relation to Oral and Systemic Diseases. Front. Oral Health 2022, 3, 897115. [Google Scholar] [CrossRef]
- Vahapoglu, B.; Erskine, E.; Gultekin Subasi, B.; Capanoglu, E. Recent Studies on Berry Bioactives and Their Health-Promoting Roles. Molecules 2021, 27, 108. [Google Scholar] [CrossRef]
- Stabnikova, O.; Stabnikov, V.; Paredes-López, O. Fruits of Wild-Grown Shrubs for Health Nutrition. Plant Foods Hum. Nutr. 2024, 79, 20–37. [Google Scholar] [CrossRef]
- Zheng, W.; Wang, S.Y. Oxygen radical absorbing capacity of phenolics in blueberries, cranberries, chokeberries, and lingonberries. J. Agric. Food Chem. 2003, 51, 502–509. [Google Scholar] [CrossRef] [PubMed]
- Mortaş, H.; Şanlıer, N. Nutritional evaluation of commonly consumed berries: Composition and health effects. Fruits 2017, 72, 5–23. [Google Scholar] [CrossRef] [PubMed]
- Olas, B. Berry Phenolic Antioxidants—Implications for Human Health? Front. Pharmacol. 2018, 9, 78. [Google Scholar] [CrossRef]
- Nile, S.H.; Park, S.W. Edible berries: Bioactive components and their effect on human health. Nutrition 2014, 30, 134–144. [Google Scholar] [CrossRef]
- Kowalska, K. Lingonberry (Vaccinium vitis-idaea L.) Fruit as a Source of Bioactive Compounds with Health-Promoting Effects—A Review. Int. J. Mol. Sci. 2021, 22, 5126. [Google Scholar] [CrossRef]
- Mandal, M.K.; Domb, A.J. Antimicrobial Activities of Natural Bioactive Polyphenols. Pharmaceutics 2024, 16, 718. [Google Scholar] [CrossRef] [PubMed]
- Jiang, H.; Zhang, W.; Li, X.; Xu, Y.; Cao, J.; Jiang, W. The anti-obesogenic effects of dietary berry fruits: A review. Food Res. Int. 2021, 147, 110539. [Google Scholar] [CrossRef] [PubMed]
- Sun, L.; Miao, M. Dietary polyphenols modulate starch digestion and glycaemic level: A review. Crit. Rev. Food Sci. Nutr. 2020, 60, 541–555. [Google Scholar] [CrossRef] [PubMed]
- Di Lorenzo, C.; Colombo, F.; Biella, S.; Stockley, C.; Restani, P. Polyphenols and Human Health: The Role of Bioavailability. Nutrients 2021, 13, 273. [Google Scholar] [CrossRef] [PubMed]
- Yang, F.; Chen, C.; Ni, D.; Yang, Y.; Tian, J.; Li, Y.; Chen, S.; Ye, X.; Wang, L. Effects of Fermentation on Bioactivity and the Composition of Polyphenols Contained in Polyphenol-Rich Foods: A Review. Foods 2023, 12, 3315. [Google Scholar] [CrossRef]
- Hervert-Hernández, D.; Goñi, I. Dietary Polyphenols and Human Gut Microbiota: A Review. Food Rev. Int. 2011, 27, 154–169. [Google Scholar] [CrossRef]
- Brown, E.M.; Gill, C.I.R.; Stewart, D.; McDougall, G.J. Lingonberries (Vaccinium vitis-idaea L) and blueberries (Vaccinium corymbosum) contain discrete epicatechin anthocyanin derivatives linked by ethyl bridges. J. Berry Res. 2016, 6, 13–23. [Google Scholar] [CrossRef]
- Puišo, J.; Jonkuvienė, D.; Mačionienė, I.; Šalomskienė, J.; Jasutienė, I.; Kondrotas, R. Biosynthesis of silver nanoparticles using lingonberry and cranberry juices and their antimicrobial activity. Colloids Surf. B Biointerfaces 2014, 121, 214–221. [Google Scholar] [CrossRef]

Disclaimer/Publisher’s Note: The statements, opinions and data contained in all publications are solely those of the individual author(s) and contributor(s) and not of MDPI and/or the editor(s). MDPI and/or the editor(s) disclaim responsibility for any injury to people or property resulting from any ideas, methods, instructions or products referred to in the content. |
© 2024 by the authors. Licensee MDPI, Basel, Switzerland. This article is an open access article distributed under the terms and conditions of the Creative Commons Attribution (CC BY) license (https://creativecommons.org/licenses/by/4.0/).
Share and Cite
Pärnänen, P.; Niikko, S.; Lähteenmäki, H.; Räisänen, I.T.; Tervahartiala, T.; Sorsa, T.; Ranki, A. Lingonberry (Vaccinium vitis-idaea L.) Fruit Phenolic Bioactivities—A Review of In Vitro and In Vivo Human Studies. Microorganisms 2024, 12, 1850. https://doi.org/10.3390/microorganisms12091850
Pärnänen P, Niikko S, Lähteenmäki H, Räisänen IT, Tervahartiala T, Sorsa T, Ranki A. Lingonberry (Vaccinium vitis-idaea L.) Fruit Phenolic Bioactivities—A Review of In Vitro and In Vivo Human Studies. Microorganisms. 2024; 12(9):1850. https://doi.org/10.3390/microorganisms12091850
Chicago/Turabian StylePärnänen, Pirjo, Sari Niikko, Hanna Lähteenmäki, Ismo T. Räisänen, Taina Tervahartiala, Timo Sorsa, and Annamari Ranki. 2024. "Lingonberry (Vaccinium vitis-idaea L.) Fruit Phenolic Bioactivities—A Review of In Vitro and In Vivo Human Studies" Microorganisms 12, no. 9: 1850. https://doi.org/10.3390/microorganisms12091850
APA StylePärnänen, P., Niikko, S., Lähteenmäki, H., Räisänen, I. T., Tervahartiala, T., Sorsa, T., & Ranki, A. (2024). Lingonberry (Vaccinium vitis-idaea L.) Fruit Phenolic Bioactivities—A Review of In Vitro and In Vivo Human Studies. Microorganisms, 12(9), 1850. https://doi.org/10.3390/microorganisms12091850

